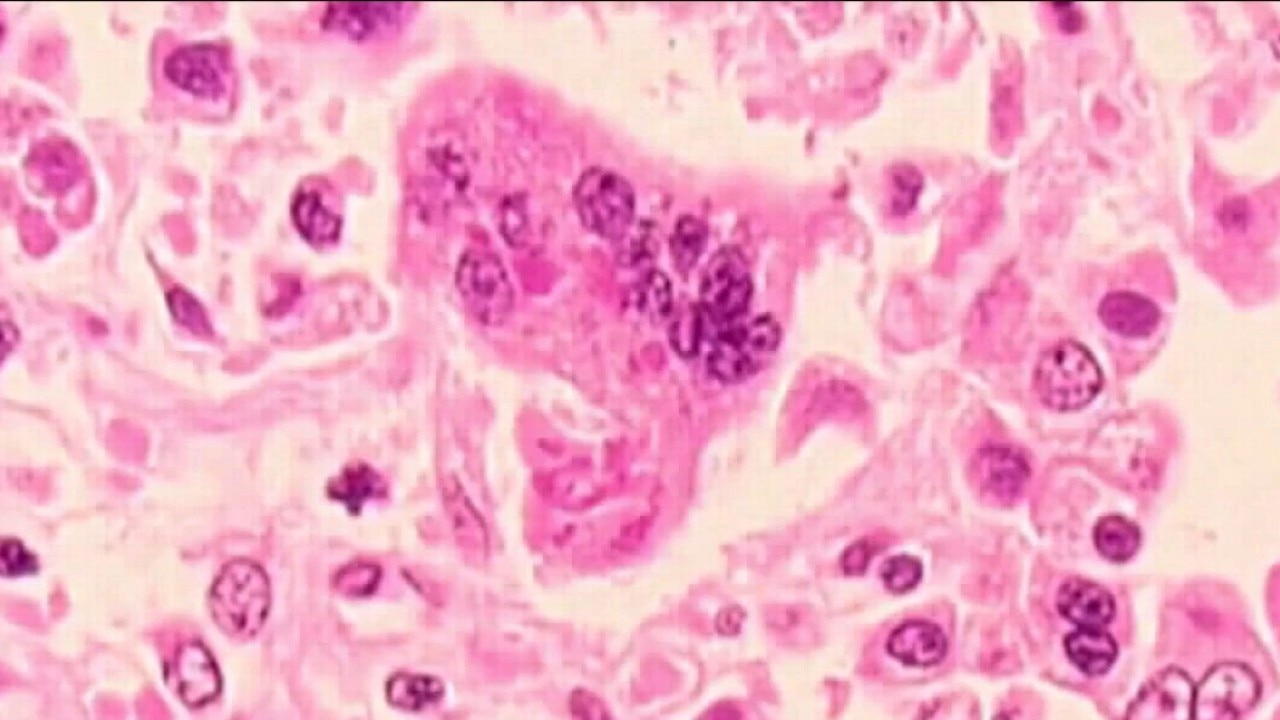

6 Milwaukee residents potentially exposed to measles on flight
The Wisconsin Department of Health Services has identified six Milwaukee residents potentially exposed to the measles on a recent flight that traveled to Mitchell International Airport.
Top Videos
6 Milwaukee residents potentially exposed to measles on flight

Tornado-warned storm moves through Dodge County

Milwaukee leaders discuss replacing We Energies

Town of Delafield man accused of trying to kill dad

Kwik Trip Fun Run 2026: Help raise money for veterans

Racing with a purpose

Milwaukee Night Market canceled, small businesses impacted

Moran’s Pub in South Milwaukee; historic spot ultimate home base for soccer fans

Giannis trade to Miami Heat: Alex Lasry perspective

Feeding America Eastern Wisconsin on Bobby Portis' impact

Judge blocks Milwaukee food truck curfew

Summerfest watersport rentals for fans

June is cataract awareness month

Taekwondo instructor headed to trial

'Ice Out of West Allis Coalition' concerns over new policy

Friend, former Bucks broadcaster speaks on Giannis trade

Bucks draft: Fans react to picks, Giannis Antetokounmpo trade report

Giannis trade news hits young Antetokounmpo Academy athletes

Beyond Basketball: Giannis' faith-filled connection with Bucks chaplain and Evolve Church

Water skiing for wounded vets

Giannis trade to Miami Heat: Economic impact of #34

Giannis trade to Miami Heat: What's next for Milwaukee Bucks?

Giannis trade to Miami Heat; reaction from Milwaukee youth

GIANNIS TRADE: What's next for Milwaukee

Milwaukee Mayor delivers remarks on Giannis


